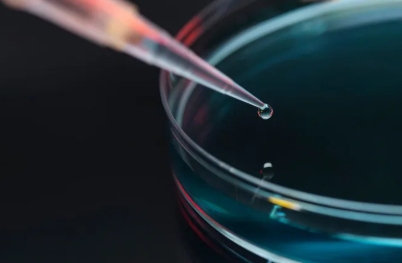
鞍山妇儿医院做试管怎么样，鞍山妇儿医院生殖科移植新鲜胚胎为什么那么贵？

鞍山女子医院的生殖中心开展了体外受精-胚胎移植、卵胞浆内单精子注射、睾丸附睾显微取精、囊胚培养等项目,不孕不育患者还可以到医院做胚胎移植手术助孕,但费用相对较高,可能是以下因素造成的:
1、药物品种不同:主要分为进口药和国产药,进口药和国产药的价格和性能有很大不同,费用也存在差异;
2、医院手术和实验室操作不同:在试管助孕期间,采用的治疗方法和费用采集不同,例如一代、二代、三代试管费用都存在一定的差异;
3、排卵方案不同,价格区别:目前,试管常见的排卵方案有:长方案、短方案这两种,医生根据患者的身体情况,选择了不同的方案,不同方案之间的药物种类用量差别很大,长方案需要用到更多的排卵药物,因而费用上的差别很大;4、疾病治疗费用:有些女性患有影响试管成功率的疾病,如宫腔内粘连、慢性盆腔炎、输卵管炎等疾病,在进行试管婴儿生育前,需要做一些额外的治疗。
一般来说,年龄是影响试管婴儿成败的关键因素,尤其是女性,年龄越大,卵巢功能越差,试管婴儿成功率越低,这在不经意间就加重了经济负担,如果想省钱,做试管还需趁早。另外,鞍山女子医院胚胎移植是否免费并不明确,建议患者询问医生,并在治疗期间谨遵医嘱,积极配合医生,戒烟戒酒,规律作息,适当运动,调整心态,这样可以节省试管费用。